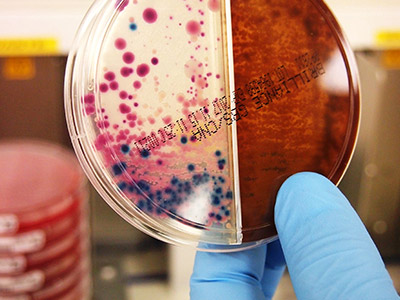
Image Description

View the new Tube Guide and Swab Guides. You can also order hard copies via our Order Form.
How can we help today?
OUR SERVICES
ABOUT
Austin Pathology
Austin Pathology is committed to the provision of high quality, comprehensive, evidence based pathology services in a timely, cost effective and ethical manner, to meet the needs of our customers.
Read More

We ensure thorough training and professional development of our staff, while maintaining a high level of activity in research and education.
Read More